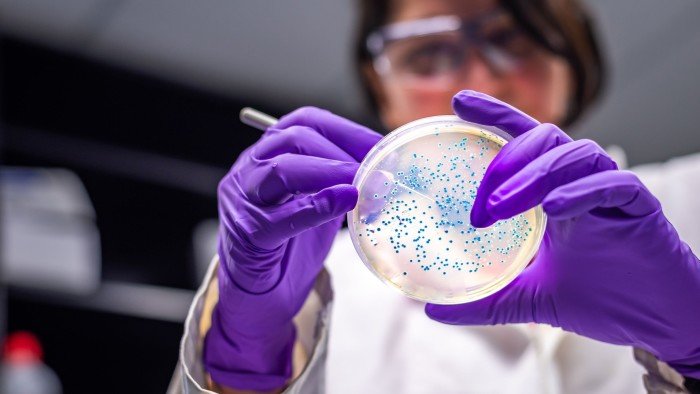

Tuberculosis rethink; fears for HIV progress; AI potential against resistant bacteria; UK boosts wastewater tests; rebuilding immunity to superbugs; insect-borne diseases threat; Chagas disease explainer
Subscribe to Updates
Get the latest creative news from FooBar about art, design and business.
Related Posts
Add A Comment